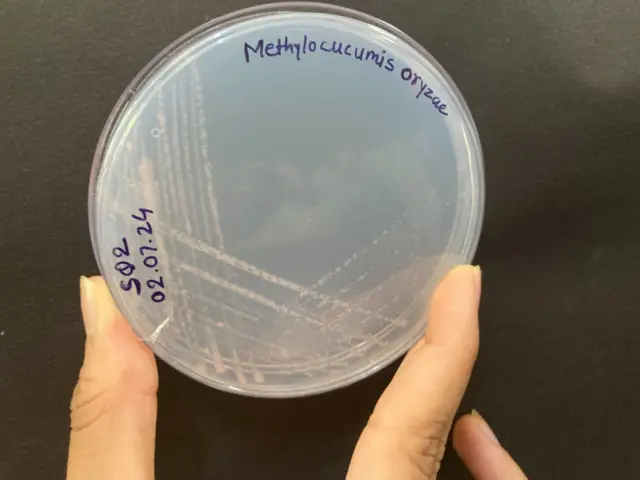
मिथेन

मिथेनला खाणाऱ्या जीवाणूचा भारतीय अवतार भातशेतीला कसा मदत करेल?

फोटो स्रोत, Getty Images
- Author, जान्हवी मुळे
- Role, बीबीसी मराठी प्रतिनिधी
- वाचन वेळ: 5 मिनिटे
उष्णतेच्या लाटा, अचानक येणारे पूर आणि शक्तिशाली चक्रीवादळं. हवामान बदलाचे असे दुष्परिणाम सगळीकडे दिसत आहेत. पण त्यावर आता काही जीवाणू उपाय ठरू शकतात.
ही कुठली कल्पना नाही. पुण्यातल्या आघारकर संशोधन संस्था (ARI) मधल्या शास्त्रज्ञांनी अशा एका जीवाणूवर संशोधन केलं आहे.
डॉ. मोनाली रहाळकर यांच्या मार्गदर्शनाखालील टीमनं महाराष्ट्रात, पश्चिम घाटाच्या प्रदेशात आढळून आलेली ही जीवाणूची नवी प्रजाती असल्याचं सिद्ध केलं आहे.
हे जीवाणू मिथेनोट्रोफ आहेत, म्हणजे ते मिथेन वायू खाऊन जगतात. पृथ्वीवरचं तापमान ज्या कार्बनजन्य वायूंमुळे वाढतं, त्यातला मिथेन हा एक प्रमुख वायू आहे.
पुण्यातल्या टीमनं दहा वर्षांपासून या जीवाणूवर संशोधन केलं त्यांनी शोधलेली एक प्रजाती कशी विशेष आहे, यावर शोधनिबंध प्रकाशित केला आहे.
त्यानंतर हे संशोधन चर्चेत आलं आहे, कारण ही नवी प्रजाती 'एंडेमिक' म्हणजे वैशिष्ट्यपूर्ण स्थानिक प्रजाती असू शकते, असं. हवामान बदलाचा सामना करण्यासाठीच नाही तर शेतीसाठीही हे जीवाणू मदत करू शकतात.
मिथेन आणि हवामान बदल
जागतिक तापमानवाढीसाठी कारणीभूत ठरणाऱ्या वायूंमध्ये कार्बन डायऑक्साईडननंतर मिथेन हा दुसरा सर्वांत महत्त्वाचा वायू आहे.
मिथेनचं प्रमाण कार्बन डायऑक्साईडपेक्षा तुलनेनं कमी असलं, तरी मिथेनचा तापमानावर वीस वर्षांमध्ये होणारा परिणाम हा कार्बन डायऑक्साईडपेक्षा सुमारे 80 पटीने जास्त असतो.

फोटो स्रोत, Monali Rahalkar/ARI
सध्या वाढलेल्या तापमानापैकी एक तृतीयांश तापमानवाढ ही मिथेनमुळे झाली आहे, असं संयुक्त राष्ट्रांची पर्यावरण संस्था UNEP चा अहवाल सांगतो.
त्यामुळेच मिथेनचं उत्सर्जन कमी करणं आणि तो शोषून घेतला जाईल अशा उपाययोजना करणं महत्त्वाचं ठरतं.
नैसर्गिकरीत्या पाणथळ जागा, कचऱ्याची मोठी डंपिंग ग्राऊंड्स, कुजणाऱ्या वस्तू आणि रवंथ करणाऱ्या प्राण्यांचे ढेकर यांतून मिथेन बाहेर पडतो.
पण तेलविहीरींमधून जीवाश्म इंधन काढताना तसंच भातशेती आणि मोठ्या प्रमाणात पशुपालन अशा मानवी क्रियांमुळे मोठ्या प्रमाणात या वायूचं उत्सर्जन होतं.
आर्क्टिक आणि अंटार्क्टिक प्रदेशातलं शतकांपासून गोठलेलं हिम वितळतं, तेव्हा त्यातूनही मिथेन उत्सर्जन होतं. जगभरात काही ठिकाणी मिथॅनोट्रॉफ्सवर अलीकडच्या काळात अभ्यास केला जातो आहे.
या वायूचं वाढतं प्रमाण नियंत्रणात कसं आणायचं, त्यासाठी मिथेनवर जगणाऱ्या जीवाणूंचा वापर करता येईल का यावर संशोधन सुरू आहे. भारतात आता अशा जीवाणूंची नवी प्रजाती संशोधकांना सापडली आहे.
अशा जीवाणूंना मिथॅनोट्रोफ किंवा मिथेन-ऑक्सिडायझिंग जीवाणू म्हणून ओळखलं जातं.

डॉ. मोनाली रहाळकर सांगतात, “आपण जगण्यासाठी ऑक्सिजन आणि अन्नाचं सेवन करतो. पण मिथॅनोट्रोफ्स अन्न आणि ऊर्जेसाठी मिथेनचा वापर करतात.”
हे जीवाणू मिथेनचं रूपांतर आधी मिथेनॉल मग फार्माल्डिहाईड, फॉर्मिक अॅसिडमध्ये आणि अखेर कार्बन डायऑक्साईडमध्ये करतात. पण हा कार्बन डायऑक्साईड मूळ मिथेनपेक्षा अत्यल्प प्रमाणात असतो.
“या प्रक्रियेत पाणीही तयार होतं. तसंच बायोमास (जैविक भार) तयार होतं आणि नायट्रोजन म्हणजे नत्राचे स्थिरीकरण होते, जे शेतजमिनीसाठीही फायद्याचे असते.”
संशोधकांना काय आढळलं?
डॉ. मोनाली रहाळकर ARI मध्ये शास्त्रज्ञ आहेत आणि गेल्या दशकभरापासून मिथॅनोट्रॉफ्सचा अभ्यास करत आहेत. केंद्र सरकारच्या डिपार्टमेंट ऑफ सायन्स आणि डिपार्टमेंट ऑफ बायोटेक्नॉलॉजीच्या सहाय्यानं त्यांच्या टीमनं हे संशोधन केलं आहे.
डॉ. रहाळकर यांच्या टीमनं 2013 पासून हे संशोधन सुरू केलं. मुळशी, भोर, मावळ, नारायणगाव या परिसरातून भाताच्या शेतांमधून जीवाणूंचे नमुने जमा केले होते.
त्यातला मिथॅनोट्रॉफ जीवाणूची एक वेगळी प्रजाती 2015 साली त्यांना सापडली आणि 2018 साली पहिल्यांदा त्यांचं संशोधन प्रकाशित झालं होतं.
या नव्या जीवाणूला ‘मिथायलोक्युक्युमिस ओरायझे’ असं नाव देण्यात आलं. त्यामागचं कारण डॉ. रहाळकर स्पष्ट करतात.


“क्युक्युमस, कारण हा जीवाणू क्युकुंबर म्हणजे काकडीसारखा दिसतो आणि ओरायझे कारण भाताच्या शेतात तो आम्हाला पहिल्यांदा आढळून आला.
“मिथेनवर जगणाऱ्या इतर जीवाणूंमध्ये आणि या जीवाणूमध्ये केवळ 94 टक्केच साम्य असल्याचं जीनोम सिक्वेंसिंगद्वारा दिसून आलं. त्यामुळे ही वेगळी प्रजाती असल्याचं सिद्ध झालं.”

फोटो स्रोत, Monali Rahalkar/ARI
इतर जीवाणूंपेक्षा हा जीवाणू तुलनेनं मोठा म्हणजे साधारण 3-6 µm (3 ते6 मायक्रॉन) एवढा असतो. आता एक मायक्रॉन म्हणजे म्हणजे मिलीमीटरचाही एक हजारावा भाग.
हा जीवाणू मध्यम तापमानात जगतो. पण तो 37 अंश सेल्सियसपेक्षा जास्त तापमानात जगू शकत नाही.
पुढे लॉकडाऊनच्या काळात पुण्याच्या वेताळ टेकडी परिसरातही त्यांना हे जीवाणू आढळून आले.
“आम्ही तेव्हा वेताळ टेकडीवरच्या खाणीच्या परिसरात फिरायला गेलो होतो आणि तिथले काही सॅम्पल्स गोळा केले. त्यातही हा नवा जीवाणू आढळून आला. गेल्या तीन वर्षांत इथल्या जीवाणूंचा अभ्यास केला, त्यांचे कल्चर्स बनवले,” अशी माहिती डॉ. रहाळकर देतात.
त्यांची प्रयोगशाळा देशातली एकमेव प्रयोगशाळा आहे जिथे या जीवाणूंचं यशस्वीरीत्या ‘कल्चर’ केलं जातंय.
फोटो स्रोत, Monali Rahalkar/ARI
आघारकर संशोधन संस्थेच्या टीमकडे आता साधारण 80 हून अधिक कल्चर्स आहेत. “हे नमुने सांभाळणं ही सर्वांत मोठी कसरत आहे. कारण हे नमुने नुसते फ्रीजरमध्ये टाकून दिले की झालं, असं नाही. त्यांची फार काळजी घ्यावी लागते,” डॉ. रहाळकर सांगतात.
हा जीवाणू सापडल्यानंतरच्या दहा वर्षांत मिथायलोक्युक्युमस ओरायझेशी साधर्म्य असणारा दुसरा जीवाणूंचा स्ट्रेन इतर कुठल्या देशात किंवा जगाच्या इतर भागात आढळलेल्या नाही.
ही गोष्ट महत्त्वाची आहे, कारण त्यामुळे हा जीवाणू एंडेमिक आहे म्हणजे केवळ भारतातच आढळून येत असल्याचं सिद्ध होतं.
आजवर मायक्रोबियल इकॉलॉजी, फ्राँटियर्स ऑफ मायक्रोबॉलॉजी अशा प्रकाशनांमध्ये हे संशोधन प्रसिद्ध झालं आहे.
हा जीवाणू का महत्त्वाचा?
मिथॅनोट्रॉफ जीवाणू हवेतल्या मिथेनचं विघटन करून हवामान बदलाला आळा घालण्यासाठी मदत करतात, तसंच त्यांच्यामुळे शेतीलाही फायदा होतो.
सध्या ARI मधले संशोधक भारतात आढळणाऱ्या मिथॅनोट्रॉफ्सचा उपयोग कसा करता येईल, यावर संशोधन करत आहेत.

भारतात साधारण अर्ध्या लोकसंख्येसाठी तांदूळ प्रमुख अन्न आहे. पण भाताच्या शेतातून मिथेनचं उत्सर्जनही मोठ्या प्रमाणात होतं. (जगभरात एकूण मिथेन उत्सर्जनात भातशेतीचा वाटा 8-10 टक्के आहे.)
ARI मधल्या टीमनं मिथायलोक्युकुमिस आरोयझे आणि इतर मिथॅनट्रॉफ्सचा इंद्रायणी तांदळाच्या पिकावर काय परिणाम होतो आहे, याचा अभ्यास केला आहे. या जीवाणूंचे कल्चर वापरल्यानं भाताच्या वाढीला मदत होते आणि भात बहरण्याचा कालावधीही कमी होतो असं संशोधकांना दिसून आलं आहे.

फोटो स्रोत, Monali Rahalkar/ARI
पण शेतीसाठी मोठ्या प्रमाणात या जीवाणूची निर्मिती करायची, तर त्यात काही अडथळे आहेत. कारण हा जीवाणू वाढण्याचा वेग बराच कमी कमी आहे.
या जीवाणूंचा वापर शेतीसाठी मोठ्या प्रमाणात करता येईल का, त्यासाठी त्यांची पैदास करता येईल का आणि त्यातून खतासारखं उत्पादन तयार केलं, तर ते शेतकऱ्यांना परवडेल का, यावरही विचार सुरू आहे.
तसंच डंपिग ग्राउंडमधल्या कचऱ्यातून होणाऱ्या मिथेन उत्सर्जनाला आळा घालण्यासाठी या जीवाणूचा वापर करता येईल का याचा अभ्यास सुरू आहे.
बीबीसीसाठी कलेक्टिव्ह न्यूजरूमचे प्रकाशन.











